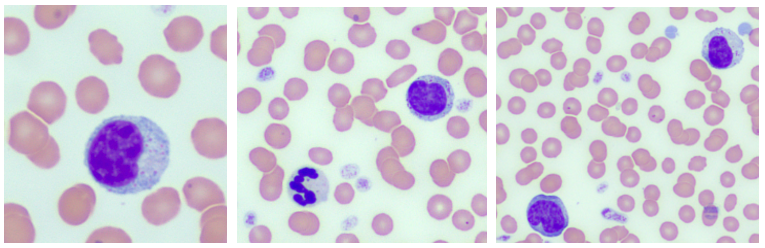
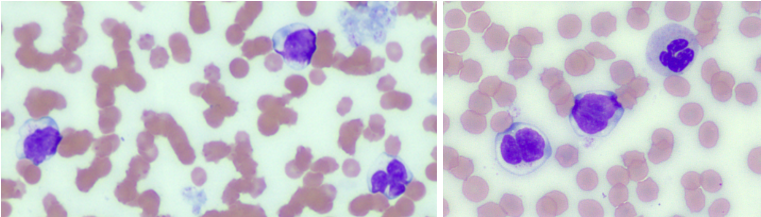

Why fresh smears are so IMPORTANT
Fresh smears allow for better assessment of cell morphology. Some key reasons include:
- Courier delays – Sometimes samples take a while to reach the lab, and cells in EDTA can start to break down during the delay.
- Warm weather – Heat speeds up cell deterioration; fresh smears help maintain diagnostic quality.
- Immature cells are fragile – These can break down even more quickly in transit; a smear made immediately after blood collection preserves their structure.
- Band Neutrophils & Toxic Changes – These changes are easier to detect on fresh smears before cells begin to deteriorate. With cows especially, it becomes harder to tell between Monocytes and Band Neutrophils.
- If you forgot to make a smear at the time of collection – It can still be made before the sample is sent; remember it will still be fresher than when it arrives at the lab after a day on the courier.
- If anticipating delays before couriering samples – Place blood samples in the fridge; however, the blood smear should remain at room temperature (never place the blood smear in the fridge).
When is a fresh smear a MUST
Some examples for when submission of a fresh smear may be of particular diagnostic importance include:
- When the animal has swollen lymph nodes or are a clinical suspect for lymphoma
- When it is a follow up case for previously diagnosed lymphoma / pre-chemo check
- Sick cows
EXAMPLES FROM THE LAB
Cow with band neutrophils:

Above is an image from a fresh smear (made and submitted by the clinic) of a cow with band neutrophils and marked neutrophilic toxic changes.
In contrast, the two images below are from the same blood but made a day later when the sample arrived at the laboratory. Toxic neutrophils and band neutrophils degrade faster than mature neutrophils and are therefore more difficult to identify in smears made from aged blood.

Cow with blast cells:

The images above are from a fresh smear. It shows beautiful intact blast cells on the left. The image on the right is taken in the tail of the smear and shows cells damaged during the smearing process.
The two images below demonstrate the degeneration that has taken place in transit, where only a few cells remain intact. The final image underneath shows the exaggerated degeneration in the tail of the smear. Without the fresh smear, it is hard to properly assess the morphology of the cells.


Dog with large granular lymphocytes:
The three images above show what large granular lymphocytes (LGLs) look like in a fresh smear.
Give them a day and they look like those in the images below, or even worse after a weekend or a public holiday. We highly recommend, for your patient and our peace of mind, that you always send a fresh smear when lymphoma ( or leukaemia) is suspected.